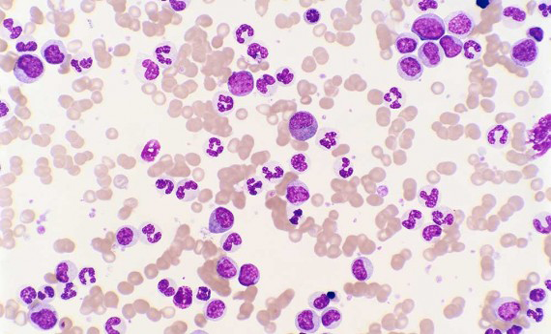

Dana Taylor
Authored Items
By Dana Taylor
November 2022 – Lung Cancer
Lung cancer is divided into 2 main categories that require different therapies. Most of the new therapies are for the common type, but recently, immunotherapy has shown promise for this less common lung cancer type. Read More ›
By Dana Taylor
November 2021 – Lung Cancer
Although most of the drugs being developed for lung cancer these days are for non–small-cell lung cancer (NSCLC), there may be a shift on the horizon as new treatment options emerge for patients with small-cell lung cancer. Read More ›
By Dana Taylor
November 2021 – Lung Cancer
It has become increasingly clear that lung cancer can be caused by different factors, including some environmental chemicals. Lung cancer in never smokers under the microscope. Read More ›
By Dana Taylor
July 2021 – Immunotherapy
Two experts discuss the advances made in lung cancer with the introduction of new immunotherapies, which have extended life for patients, and why testing for biomarkers is crucial. Read More ›
By Dana Taylor
April 2021 Vol 7 No 2
Short answer: Yes. According to ESMO, the current evidence shows that mRNA vaccines against COVID-19 are safe for patients with cancer who are receiving immunosuppressive therapy. Read More ›
By Dana Taylor
November 2020 – Lung Cancer
At the October 2020 conference of the European Society for Medical Oncology (ESMO), researchers presented information on new or recently approved targeted therapies and immunotherapies for lung cancer. Read More ›

By Dana Taylor
August 2020 – Immunotherapy
Not sure what immunotherapy is and how it works? Read about the cellular mechanism and the various types of immunotherapies, including those that use your own immune system to destroy cancer cells. This article also addresses the side effects of immunotherapy. Read More ›
By Dana Taylor
August 2020 Vol 6 No 4
Results of a recent study show that the use of Imbruvica plus Venclexta in patients with CLL who had not received any previous therapy for CLL had long-term remissions of the disease.
Read More ›
By Dana Taylor
June 2020 Vol 6 No 3
The FDA approved a new Bruton tyrosine kinase (or BTK), Calquence, for first-line treatment of patients with CLL.
Read More ›
By Dana Taylor
May 2020 – Biomarkers & Genetic Testing
Breast cancer is the second
most common cancer
among women, but it
is important to remember
that men can also have breast
cancer. Recent advances in
therapy have led to the discovery
of specific biologic markers
(biomarkers) in cancer cells,
which has further led to the development
of drugs known as
targeted therapies. Read More ›
By Dana Taylor
February 2020 Vol 6 No 1
Calquence, a new-generation targeted therapy recently approved for the treatment of CLL, has shown good results in a 3-drug combination therapy. Read More ›

By Dana Taylor
February 2020 Vol 6 No 1
A new study using a combination of the 2 oral drugs, Copiktra and Venclexta, showed promising results for patients with chronic lymphocytic leukemia (CLL) or small lymphocytic lymphoma. Read More ›
By Dana Taylor
February 2020 Vol 6 No 1
Brukinsa, which was approved for use in patients with mantle-cell leukemia in late 2019, has also showed promising results in 2 recent clinical trials of patients with chronic lymphocytic leukemia (CLL) or small lymphocytic lymphoma (SLL), including patients with high-risk genetic abnormalities. Read More ›

By Dana Taylor
December 2019 Vol 5 No 6
Among Americans diagnosed with multiple myeloma, black and Hispanic patients receive their first treatment about 3 months later than white patients. Delays in treatment means unnecessary complications. Closing this racial gap is therefore paramount. Read More ›
By Dana Taylor
August 2019 Vol 5 No 4
A new study makes clear that limited access to health insurance or insufficient insurance coverage accounts for much of the disparity in outcomes seen between black and white patients with cancer in the United States. Read More ›
By Dana Taylor
June 2019 Vol 5 No 3
Chronic lymphocytic leukemia (CLL) is the most common type of leukemia in adults. Recently, several new drug combinations without chemotherapy have been approved by the FDA for patients with CLL, providing patients new options when their cancer stops responding to current treatment. Read More ›
By Dana Taylor
April 2019 Vol 5 No 2
Results of a recent study showed that using the targeted therapy Imbruvica (ibrutinib) as the first treatment in older adults with CLL was better than the combination of chemotherapy plus immunotherapy in slowing the progression of the disease. Read More ›
By Dana Taylor
February 2019 Vol 5 No 1
Triple-negative breast cancer has few treatment options. Promising results from recent clinical trials of immunotherapy combined with chemotherapy in patients with metastatic disease may soon change the way this aggressive cancer is treated. Just after this article was written, the FDA approved this combination for patients with triple-negative breast cancer. Read More ›
By Dana Taylor
December 2018 Vol 4 No 6
New findings show that starting with a targeted therapy regimen instead of chemotherapy improves outcomes for patients with chronic lymphocytic leukemia, particularly for those under age 70. Read More ›


By Dana Taylor
October 2018 Vol 4 No 5
After many years in development, the newest type of immunotherapy known as CAR T-cell therapy (or gene therapy) is becoming a mainstream treatment in some types of blood cancer, specifically in leukemia and lymphoma. Read More ›

By Dana Taylor
August 2018 Vol 4 No 4
Immunotherapy brings new hope for patients with Merkel-cell carcinoma, a rare type of skin cancer with few treatment options. Read More ›

By Dana Taylor
May 2018 – Cancer Biomarkers and Molecular Testing
Read about important advancements in tumor biomarkers and their role in guiding treatment in some types of cancer. Read More ›

By Dana Taylor
May 2018 – Cancer Biomarkers and Molecular Testing
This first-ever direct-to-consumer genetic test can provide information on potential risks to individuals who may not have access to genetic screening, but the information may be misleading without feedback from experts. Read More ›

By Dana Taylor
April 2018 Vol 4 No 2
Patients who are receiving immunotherapy should consult with their doctor immediately if and when any side effects occur, because immune-related adverse events may occur during therapy or even after discontinuation of therapy. Read More ›

By Dana Taylor
December 2017 Vol 3 No 6
CAR T-cell therapy is a new type of immunotherapy that uses the patient’s genetically modified immune T-cells to attack cancer cells. In 2017, the FDA approved the first 2 CAR T-cell therapies for several types of blood cancer. Read More ›

By Dana Taylor
October 2017 Vol 3 No 5
Significant developments in the treatment of lung cancer were reported at the 2017 annual meeting of the European Society for Medical Oncology (ESMO) in Madrid, Spain. Read More ›

By Dana Taylor
February 2017 Vol 3 No 1
Depression among cancer survivors is associated with an increased risk for suicide, poor quality of life, increased mortality risk, delayed return to work, and more frequent use of healthcare resources, which increases their medical costs. Read More ›

By Dana Taylor
October 2016 Vol 2 No 5
Paying for cancer treatment can be challenging even for patients who have insurance. This article lists the national organizations and foundations that provide direct financial assistance for patients with cancer who are having difficulties paying for their cancer care. Read More ›

By Dana Taylor
February 2016 Vol 2 No 1
The cost of cancer care continues to climb. With the cost of newer cancer therapies reaching $10,000 to $60,000 or more a month, many patients are facing serious financial difficulties. Read More ›

By Dana Taylor
February 2016 Vol 2 No 1
The year 2015 will go down in medical history as an exceptional moment in the progress made in multiple myeloma, with 4 new drugs having been approved by the FDA and 1 drug already in use for patients with advanced disease being approved for use in all patients, including those who were just diagnosed with the disease. Although no cure is available yet, these new drugs bring significant progress to the treatment of patients with multiple myeloma. Read More ›

By Dana Taylor
October 2015 Vol 1 No 5
In September 2015, the biannual International Myeloma Workshop was held in Rome, Italy, to provide physicians and nurses up-to-date information on new therapies for patients with multiple myeloma. Read More ›

By Dana Taylor
April 2015 Vol 1 No 2
In the first 3 months of 2015, new developments in myeloma drugs could have important implications for the survival and quality of life of patients with multiple myeloma. Read More ›

By Dana Taylor
February 2015 Vol 1 No 1
Keep yourself protected from the sun at all times, even on cloudy days. Read More ›
By Dana Taylor
February 2015 Vol 1 No 1
Chronic myeloid leukemia (CML) is a blood cancer that results from a genetic abnormality that causes the production of too many white blood cells in the bone marrow. However, CML is not a genetic disease that runs in families. Read More ›